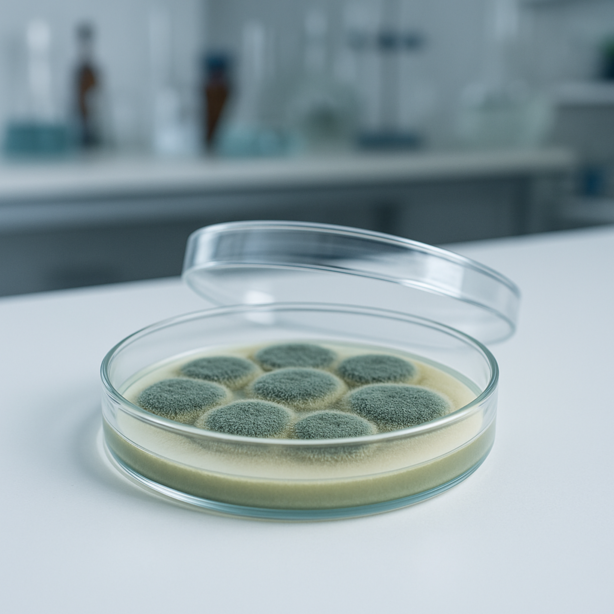
Penicillium brevicompactum | Pinselschimmel (Art)

Getxent
Penicillium brevicompactum | Pinselschimmel (Art)
Penicillium brevicompactum | Pinselschimmel (Art)
Verfügbarkeit für Abholungen konnte nicht geladen werden
Beschreibung
Für ein effektives und sicheres Training unter realen Bedingungen. Die Getxent Tubes sind mit Geruchsmolekülen echter Referenzmaterialien imprägniert. So trainierst Du immer mit dem realen Zielgeruch.
Penicillium brevicompactum ist eine häufige Pinselschimmel-Art, die bevorzugt auf Lebensmitteln und in Innenräumen vorkommt. Sie bildet kompakte, grünlich-graue Kolonien und produziert charakteristische erdige Gerüche.
- Effektiv für das Training von Spürhunden unter realen Bedingungen
- Absorbiert alle Geruchsmoleküle Deines Zielgeruch
- Der imprägnierte Zielgeruch wird gleichmäßig und kontinuierlich bis zu 6 Monate abgegeben
- Geruchsneutral und setzt nur den imprägnierten Zielgeruch Penicillium brevicompactum
Eigenschaften
7 Tage imprägniert, gebrauchsfertig mit Deinem Zielgeruch Penicillium brevicompactum
Hersteller
Kynotec
- Kultur lebender Schimmelpilze
- Schimmelpilzstämme werden durch Vergleich der DNA-Sequenzen von Markergenen identifiziert.
Technische Daten
Abmessung Tube: 8x35 mm / 0.3x1.4 in
Gewicht pro Tube: 0,93 g / 0.002 lbs
Haltbarkeit: 150 Stunden Training pro Tube / 12 Monate nach dem ersten Öffnen
Versand und Lieferung
Imprägnierte Getxent Tubes werden nach der Bestellung speziell für Dich hergestellt. So stellen wir sicher das Du ein einwandfreies Produkt erhältst. Deshalb dauert es bis zu vier Wochen bis Deine Bestellung versendet wird.
Share